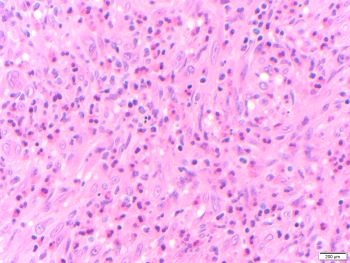
Lora_Gonzalez_Case_3_2023.jpg

Case History
A 30-year-old man presented with a well-demarcated mandibular lesion of mixed density.

What is the diagnosis?
A. Metastatic carcinoma
B. Epithelioid hemangioma
C. Angiosarcoma
D. Epithelioid hemangioendothelioma
Epithelioid hemangioma (EH) of bone is a rare benign bone tumor with destructive, locally aggressive, lytic growth and often problematic histomorphology and potential for local recurrence in one third of cases. It was first described by GC Wells and Whimster in 1969 and later named epithelioid hemangioma by Juan Rosai in the 1980s.
Epithelioid hemangioma of bone most commonly occurs in long tubular bones. The CT scan typically shows lobular architecture with expansile radiolucent, lytic, or cystic-appearing lesion with a narrow transition zone to the normal bone without osteoid matrix. In the head and neck region, epithelioid hemangiomas more frequently arise in skin and soft tissue.
Microscopic sections show a proliferation of well-formed small blood vessels with lobular arrangement and occasionally arranged around small arteries. The small vessels are formed by epithelioid endothelial cells that display abundant eosinophilic cytoplasm and enlarged round nuclei, and normal to low nuclear-to-cytoplasmic ratio; while in more cellular areas the nuclei become elongated. The stroma is hemorrhagic to edematous with mixed inflammatory cells including numerous eosinophils, which may be a clue to the diagnosis in small biopsies.
The tumor cells express endothelial markers such as CD31, CD34, FLI1, ERG and factor VIII-related antigen. In this case, immunohistochemistry was used to demonstrate that the epithelioid endothelial cells were positive for the vascular marker ERG. Most cases show rearrangement of FOS or FOSB. The histopathologic differential diagnosis should include angiosarcoma, which is not typically well demarcated, lacks the lobular architecture, shows more cytologic atypia, and has significant proliferative activity (absent in this case). Metastatic carcinoma is negative for vascular markers. Epithelioid hemangioendothelioma shows hyalinized or chondroid stroma and vacuolated cells


References
Bovee, JV, Rosenberg, AE. Epithelioid haemangioma of bone. In: WHO Classification of Tumours Editorial Board. Soft tissue and bone tumours [Internet]. Lyon (France): International Agency for Research on Cancer; 2020 [cited 2023 Feb. 15]. (WHO classification of tumours series, 5th ed.; vol. 3). Available from: https://tumourclassification.iarc.who.int/chapters/33/235.
Sbaraglia M, Bellan E, Mentzel T, Dei Tos A. The Contribution of Juan Rosai to the Pathology of Soft Tissue Tumors. Pathologica. 2021;113(5):396-409. doi:10.32074/1591-951X-
Tsuda Y, Suurmeijer AJH, Sung YS, Zhang L, Healey JH, Antonescu CR. Epithelioid hemangioma of bone harboring FOS and FOSB gene rearrangements: A clinicopathologic and molecular study. Genes Chromosomes Cancer. 2021;60(1):17-25. doi:10.1002/gcc.22898
Case contributed by: Manuel Lora Gonzalez, M.D., Assistant Professor, Anatomic Pathology, Head/Neck Section Head, UAB Pathology